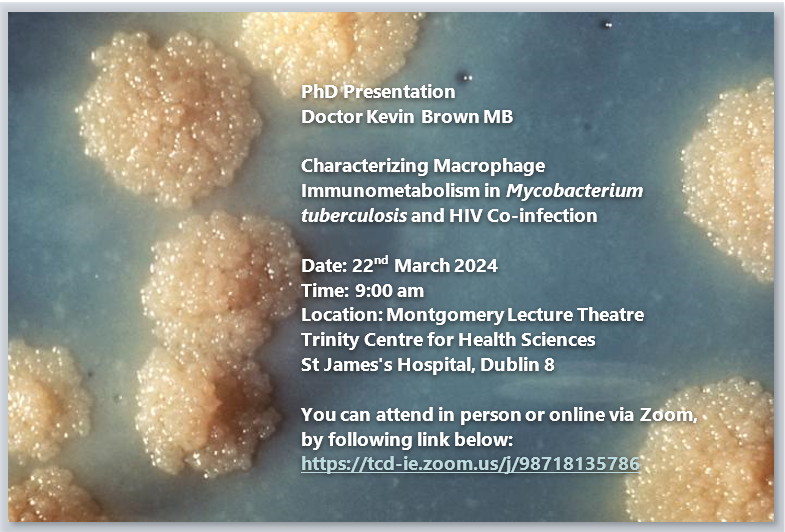

TCDClinicalMed
@medtcd
ID: 974250322632769536
15-03-2018 11:45:52
78 Tweet
104 Takipçi
76 Takip Edilen

“Policy and health-care practice addressing psychological health issues in social context and early in the life course could be effective strategies for reducing health inequalities.” New research by Sir Michael Marmot et al thelancet.com/journals/lanpu…